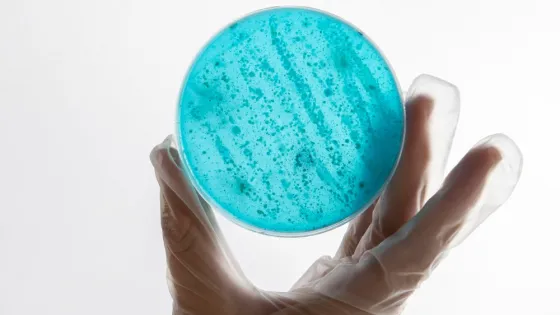
2149132688-v1

- ИИ помог создать прорывные антибиотики против гонореи и золотистого стафилококка.
- Ученые Массачусетского технологического института сгенерировали и проверили более 36 млн потенциальных соединений.
- Наиболее перспективные из них структурно отличаются от существующих препаратов и действуют через новые механизмы.
- Это поможет противостоять антибиотикорезистентности, которая приводит к 5 млн смертей ежегодно.
- Традиционные методы разработки антибиотиков не способствовали появлению принципиально новых механизмов действия.
- В ходе проекта Массачусетского технологического института «Антибиотики-ИИ» ИИ уже использовался для скрининга химических соединений.
- Теперь ИИ генерировал гипотетические молекулы, которых нет в природе.
- Исследователи проанализировали 45 млн химических фрагментов и нашли соединения, способные действовать против бактерии N. gonorrhoeae.
ИИ помог создать прорывные антибиотики против двух самых опасных инфекций
18 авг 2025
Краткий пересказ
от нейросети YandexGPT
Обложка: Изображение с сайта informburo.kz. Фото Getty Images